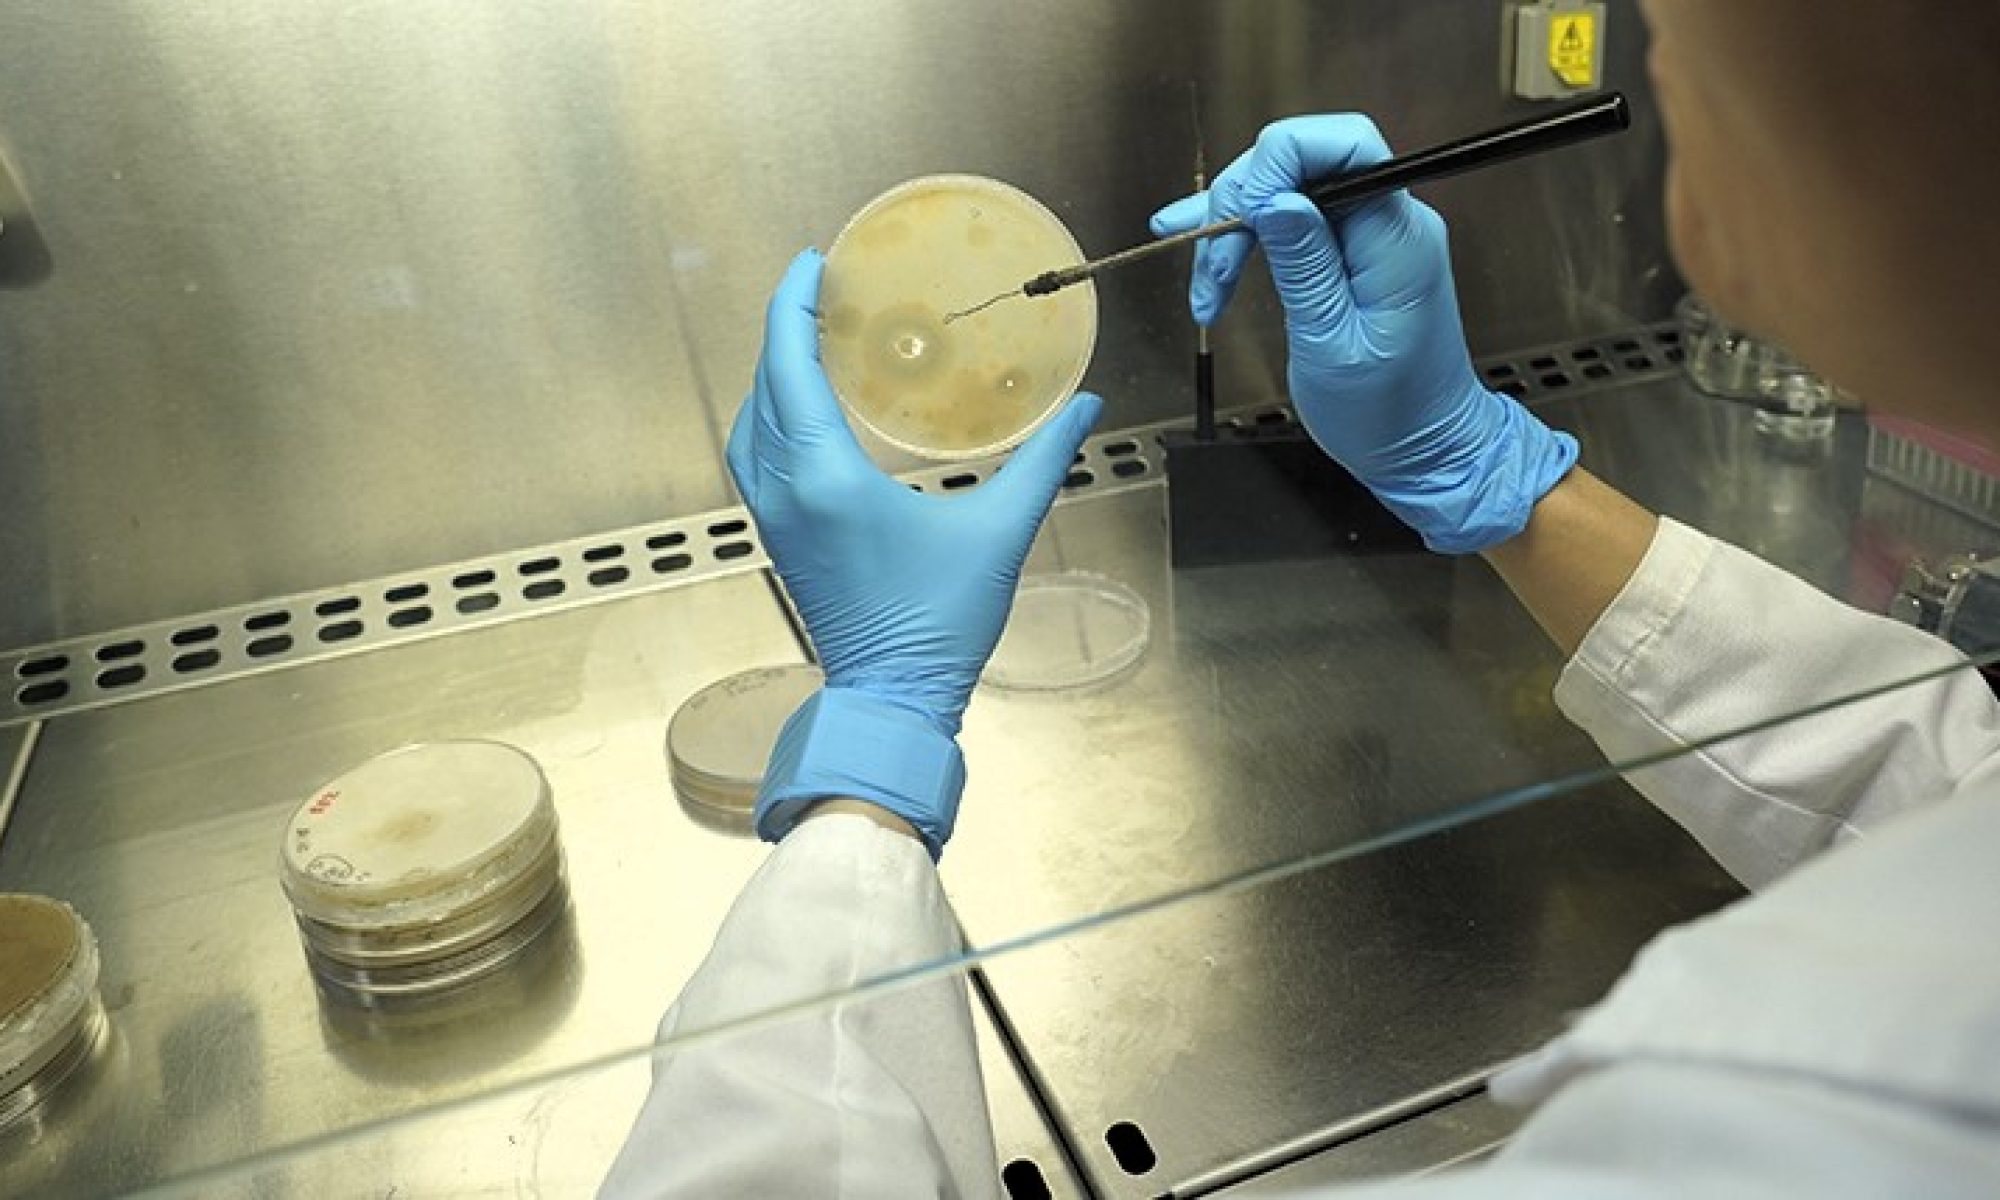

En el marco del proyecto BIOPUCRAQ, investiga cómo implementar una tecnología de craqueo biológico para degradar residuos de poliuretano procedentes de componentes de calzado que transformen la producción lineal en una economía circular dentro del sector, haciéndolo más sostenible y eficiente con los recursos. El objetivo principal del proyecto es implementar un proceso de craqueo biológico para degradar residuos de poliuretanos empleados en calzado, averiguando la capacidad de enzimas comerciales, hasta ahora no probadas en estos materiales, y aislar microorganismos con mayor potencial para la degradación de polímeros.
Esta web utiliza cookies para que podamos ofrecerte la mejor experiencia de usuario posible. La información de las cookies se almacena en tu navegador y realiza funciones tales como reconocerte cuando vuelves a nuestra web o ayudar a nuestro equipo a comprender qué secciones de la web encuentras más interesantes y útiles.